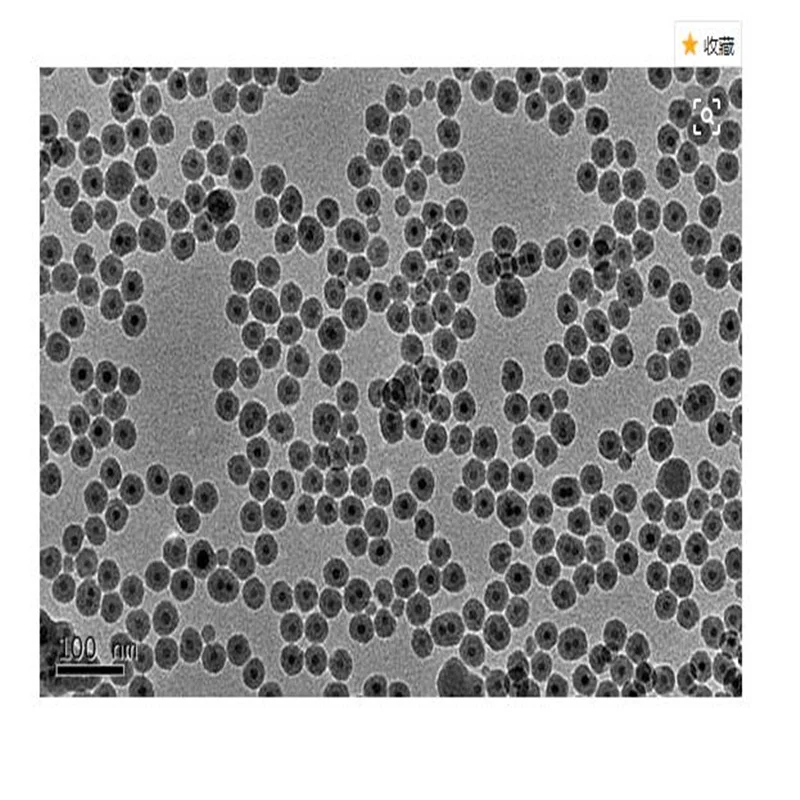

Zabawka palemka Happet K055 sizal 6cm beżowa

Zabawka palemka Happet K055 sizal 6cm beżowa
артикул: 9630098794
СОГЛАСНО НАШИМ ДАННЫМ, ЭТОТ ПРОДУКТ СЕЙЧАС НЕ ДОСТУПЕН
$0.77
Доставка из: Польша
График изменения цены & курс обмена валют
Пользователи также просматривали

$209.33
Платье-миди French Connection Cambria из хлопка с вышивкой кофейно-коричневого цвета
cdek.shopping
$60.50
Велюровый блузон для дома (2180/1), Черный;розовый;коричневый, Велюровый блузон для дома (2180/1)
intimo.com.ua
$1.83
50 шт. 6 мм автомобильные крепежи бампер брызговик грязеотталкивающий брызговик пластиковые заклепки Крепежные Зажимы крышка для Lexus для Subaru для Nissan
aliexpress.ru
$48.69
1 корпус термостата охлаждающей жидкости для автомобиля Mini для Cooper S R56 2007 - 2013 11537534521 для C4 Grand Picasso I (UA) (2006
aliexpress.ru
$10.00
Автомобильное зеркало заднего вида Mr951187, кнопка переключателя Sontrol со складной ручкой для Montero
aliexpress.ru
$8.29
Водонепроницаемая полиэстеровая занавеска для душа с рождественским оленем для ванной комнаты, 71 дюйм, 12 крючков
aliexpress.ru
$6.05
Утолщенная кровать для собаки, мягкая подстилка для кошки, подстилка для кошек, коврик для сна, одеяло для домашних животных
aliexpress.ru
$1.80
Perforated Hanging Ring for Rivet Ornament, Hollow Circular Ring, Lock Buckle, Retro Punk Style, Nail Drill Patch Decoration
aliexpress.ru
$29.28
Milwaukee 12V 9,8 Ah Lithium-batterie, Kompatibel Mit Milwaukee 12V Cordless Power Werkzeuge 48-11-2420 48-11-2440 48-11-2402
aliexpress.ru
$258.77
2023 Laatste 52V 14S6P 65000Mah 18650 1800W Lithium Batterij gebalanceerd Voertuig Elektrische Fietsscooter Driewieler
aliexpress.ru
$5.10
Motorcycle CNC Front Wheel Hub For KTM SX SX-F EXC EXC-F EXC-W XC-W 125 150 200 250 300 350 400 450 2016 2017 2018 2019 2020
aliexpress.com
$10.23
Крышка топливного бака, привод дверного замка, крепление для Audi A4 S4 B8 Avant Allroad Quattro A5 S5 Q5 RS5 RS4
aliexpress.ru
$94.98
Left Side Door Power Folding Rearview Mirror Assembly for Mercedes Benz W221 S-Class S300 S350 S400 S63 2006-2014
aliexpress.com
$9.75
Multifunctional Car Foam Cleaner - Multipurpose Bubble Cleaner Sprays, Lemon Flavor and UV Protection, Cleaning Detergent Sprays
aliexpress.com
$4.98
Fits Original pandora bracelets 925 sterling silver blue Ice flower Pendants Charm beads for jewelry making women
aliexpress.com
$10.02
POLLSTAR 100 Full Grain Men Leather Belt Pin Buckle Great for Jeans Casual Cowboy Work Wear (BT126BN)
paytmmall.com
$11.50
Women's Chiffon Dress Maxi long Dress Blushing Pink Short Sleeve Dusty Rose Color Block Backless Lace Spring & Summer Round Neck Hot Boho Belt Not Included 2021 S M L XL
miniinthebox.com
$6.29
Main Brush Side Brush Replacement Parts for Cecotec Conga 3090 Vacuum Cleaner Robot
aliexpress.com
$8.99
Girls Sport Shoes Soft Sole Colorful Leisure Children Canvas Shoes for Baby Boy Toddler Sneakers Trainers Mini Melissa Kid Shoes
aliexpress.com